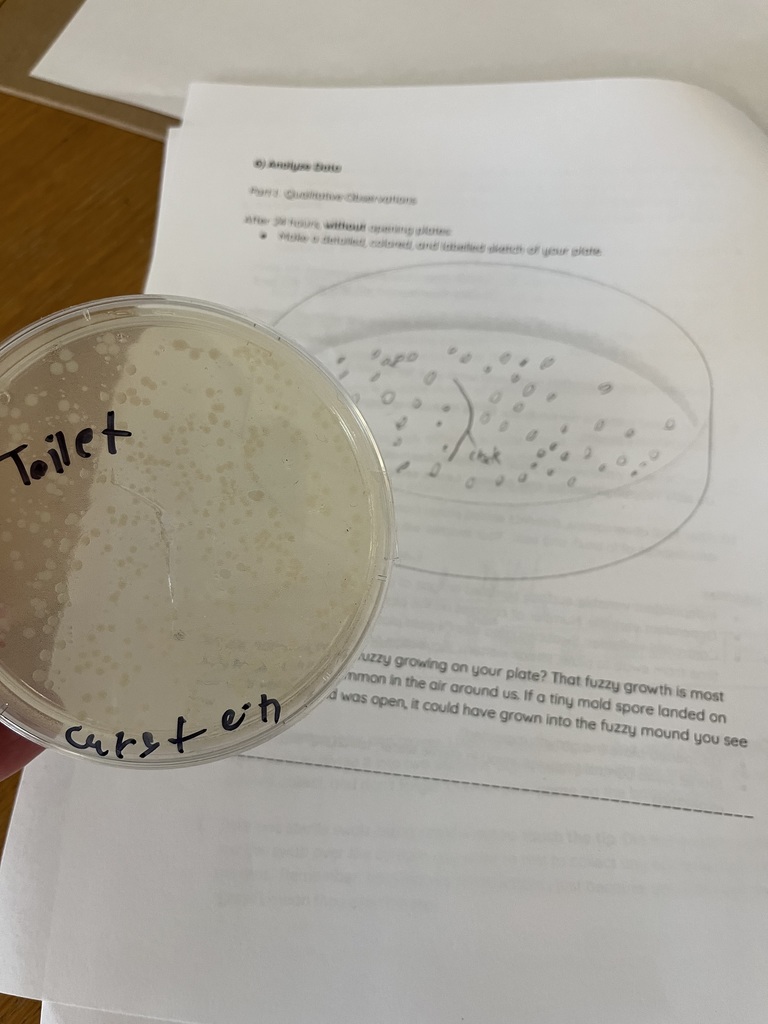
Middle School Bacterial Lab

This week, our MS students explored bacterial hot spots around the building as part of our study on communicable diseases, viruses, and bacteria.
Wishing everyone a restful — and germ-free — weekend! 😊

Middle School (6th & 7th Grade Only) :
- Teachers will contact selected families to schedule conferences for the afternoons of Monday, Nov. 24 and Wednesday, Nov. 25.
- If you do not receive a request, please join us for open conferences in the cafeteria on Monday, Nov. 17 or Tuesday, Nov. 18 between 4:00–6:30 PM.
- No sign-up required!
High School (Including 8th Grade) :
- Families are welcome to attend open conferences in the cafeteria on Monday, Nov. 17 or Tuesday, Nov. 18 from 4:00–6:30 PM.
- No sign-up needed!

An email went out earlier this week with an Amazon wish list link and a sign-up for conference meals for our staff during these long evenings. If you are able to help or donate, it would be greatly appreciated. Please stop by the CAIS PTO table during the conferences to see how CAIS families support our students and staff.
Mid-Term Conferences :
Middle School (6th & 7th Grade):
Teachers will contact select families to schedule conferences for the afternoons of Nov. 24 and Nov. 25.
If you don’t receive a scheduling request, you’re welcome to stop by the cafeteria anytime between 4:00–6:30 PM on Nov. 17 or Nov. 18 — no sign-up needed!
High School (including 8th Grade):
Families can attend open conferences in the cafeteria between 4:00–6:30 PM on Nov. 17 or Nov. 18 - No sign-up required!

Need a little extra help with food resources? Community programs are available throughout the area. Learn more and find local options here:
OCSD Community Resources:
https://www.ocsd62.org/page/community-resources

Last week four OCSD students presented to school board leaders and district leaders from across the state during the annual OSBA conference. They shared their perspectives and experiences from serving on the Superintendent Student Advisory Committee.
Watch the Hot Minute on our Youtube channel: https://youtu.be/9SnkZ5FRwGs




No school on Monday, November 10 (Grading Day) and Tuesday, November 11 (Veterans Day). Enjoy the extra time off — we’ll see you back in class on Wednesday!
Another Reminder:
Calling all future engineers!
Join OC Robotics Team 2550, Skynet, and unleash your creativity through coding, building, and teamwork! 🤖
Students ages 14–18 are welcome to join the fun.
📅 Tuesdays | 3:30–5:30 PM
📍 CAIS, 1306 12th St, Oregon City, OR 97045
🗓️ Last day for new members to join: December 16
📧 Learn more: team2550robotics@gmail.com




Join Us for the CAIS Open House & Maker Fair!
Prospective students and families are invited to explore all that CAIS has to offer! Tour our innovative spaces, learn about the tools that power our Career and Technical Education (CTE) programs, and stick around for a Q&A at the end!
📅 Thursday, November 6, 2025
📍 CAIS Campus
🕓 4:00–6:00 PM — Tours of our building and maker space
💬 4:45–5:30 PM — Q&A Session 1
💬 5:45–6:30 PM — Q&A Session 2
Please RSVP: https://tinyurl.com/mpdjzbk3

🚀 Support Our CAIS Middle School Robotics Team! 🤖
Help our amazing students gear up for their upcoming competitions! 🎉
♻️ Drop off your bottles and cans to support the team’s fundraising efforts.
📅 Date: Saturday, November 1st
🕙 Time: 10:00 AM – 12:00 PM
📍 Location: Corner of Jackson St. & 12th, Oregon City

Join OC Robotics Team 2550 Skynet and unleash your creativity through coding, building, and teamwork! 🤖
Students ages 14–18 are welcome to join the fun.
📅 Tuesdays | 3:30–5:30 PM
📍 CAIS, 1306 12th St, Oregon City, OR 97045
🗓️ Last day to join: Dec 16
📧 Learn more: team2550robotics@gmail.com

Congratulations to this week’s PBIS Winners! You've earned it — enjoy a FREE DQ Blizzard gift card as a reward for showing Positive Behavior!
REMINDER: No school for all students on Monday, October 20, 2025. Have a great three-day weekend!

🎉 BREAKING: Oregon City School District makes history as the FIRST in Clackamas County approved for high school pre-apprenticeship programs!
We're proud to pilot the Clackamas Youth Trades Initiative, partnering with Area 1 Plumbers and Pipefitters Local 290 to create a direct pipeline from classroom to career.
✅ Open to ALL OCSD high school students
✅ Preferred entry into apprenticeship applications
✅ OSHA 10 certification opportunity
✅ Professional portfolio development
✅ High-wage careers with excellent benefits
All of our high school students can take Metals classes at CAIS, gain real-world skills, and graduate ready for in-demand careers in the skilled trades.
Interested? Read more about the pilot program and our BOLI pre-approval here: https://www.ocsd62.org/article/2490032
#OCSDLeads #SkilledTrades #CareerPathways #StudentSuccess #WorkforceDevelopment #FutureReady #CTE







Don't miss out—sign up now for this season's Ski Bus!
📅 Parent Info Meeting
🗓 Tuesday, October 14
📍 CAIS Cafeteria
🕠 5:30 PM



Have a great weekend!

Donations are always welcome to keep our robots rolling!
https://www.paypal.com/donate/?hosted_button_id=GY4PR27NB6L28




We’d love for you to get involved with our Parent Teacher Organization (PTO)!
Here are some ways you can help:
- School Event Help
- Teacher Classroom Support
- Supplies for Positive Behavior Support
- Field Trip Assistance
- Staff Meals for Evening Conferences
- Fundraising for All of the Above
No matter how big or small, your involvement matters. Thank you for being part of our team!
Please return the form to the CAIS office, or email: talktocais@orecity.k12.or.us, or call 503-785-7860

